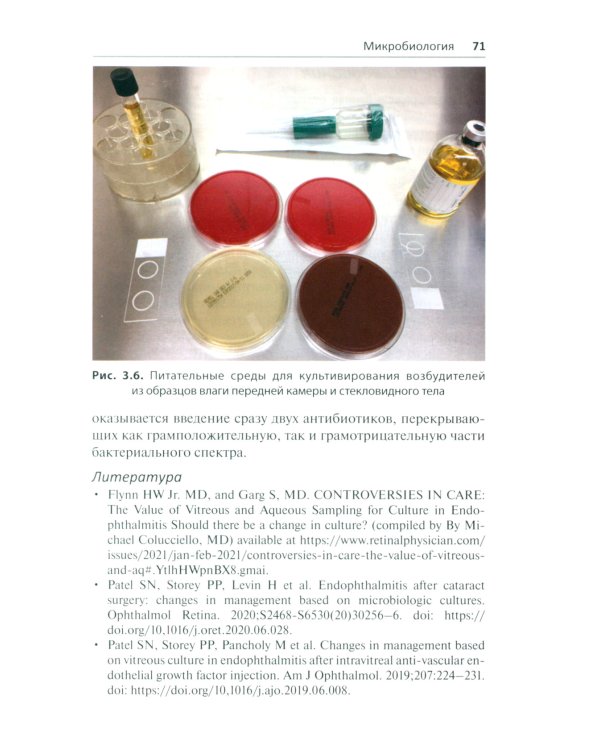
Эндофтальмит в клинической практике

Аннотация: Эндофтальмит в клинической практике
| Издательство | ГЭОТАР-Медиа |
| Автор/составитель | Флинн-мл. Х.У.;Батра Н.Р.;Шварц С.Дж. |
| Год выпуска | 2025 |
| Кол-во страниц | 240 |
| ISBN | 978-5-9704-9040-2 |
| Обложка | мягкая обложка |
| Вес | 321г |
| Формат | 21 x 13 cm |
| Тираж | 500 |
| Возрастная категория | 16+ |
В практическом руководстве представлены основные сведения о клинической диагностике и лечении эндофтальмита. В краткой форме изложены этиология, патогенез, клинические проявления, пошаговая тактика и алгоритмы лечения от момента обращения пациента и выявления первых симптомов заболевания. Подробно рассмотрены особенности применения витрэктомии pars plana, антибактериальных препаратов, методы микробиологического исследования, профилактика, анатомические и функциональные исходы и осложнения лечения. Издание иллюстрировано большим количеством фотографий, наглядно демонстрирующих клиническую картину и ее динамику в процессе лечения. Содержит сводные таблицы дозировок и способы введения традиционных противомикробных средств, данные о микробной резистентности и альтернативные схемы лечения. Предназначено врачам-офтальмологам.
Читать далее →
Бесплатная Доставка по Европе (EU)*
*Для заказов свыше 40,- евро Подробнее
Эндофтальмит в клинической практике
-37%- Производитель: ГЭОТАР-Медиа
- Модель: TEEI11699380
- ISBN 978-5-9704-9040-2
-
Наличие:
Есть в наличии
77.52€
-37%
48.84€
Нашли этот товар по более низкой цене?
Во-первых - Вы молодец!
Во-первых - Вы молодец!
Просим Вас сообщить нам:


 Google
Google